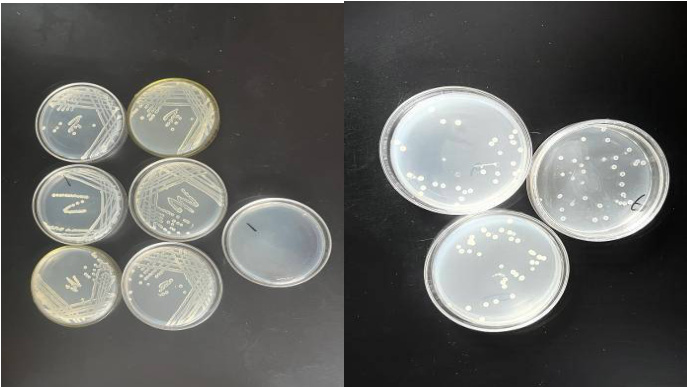

芽孢杆菌小罐发酵培养实验
刘晋瑜
云南师范大学附属中学 云南昆明 650000 身份证号码:530102200802239127
一、实验目的
本实验以通过摇瓶培养和小罐发酵的方法,观察芽孢杆菌的生长过程及芽孢形成规律,初步掌握基础微生物发酵实验流程。
二、实验原理
芽孢杆菌是一类革兰氏阳性细菌,能在不良环境中形成芽孢,具有较强的环境适应性。在培养过程中,其菌体数量和生长活性可以通过分光光度计测定菌液吸光度(OD600)进行判断。同时,采用格兰仕染色法结合光学显微镜观察可直观识别芽孢形成情况。通过对不同培养阶段的控制,能够探究其发酵产物和生长动态之间的关系。
三、实验材料与仪器
1.试剂
斜面培养基(预先配制冷冻保存)
液体培养基(成分见下)
革兰氏染色试剂
蒸馏水
盐酸6mol/L
氢氧化钠6mol/L
2.培养基配方(简化版)
(1)斜面营养培养基:
*酵母粉:5g/L
*胰蛋白胨:10g/L
*微量元素(Ca²⁺、Mg²⁺等)适量
*琼脂:15g/L
*蒸馏水定容至1L,pH调至7.0-7.2
(2)摇床液体培养基:
*豆粕水解液或豆粉:作为有机氮源
*酵母粉:5g/L
*微量元素同上
(3)小罐发酵液:
*配方与摇瓶培养基相似,提供满足微生物扩繁的条件,培养液占发酵罐容积小于等于60%
3.仪器设备
*接种环、酒精灯
*分光光度计(OD600测定,菌液稀释100倍)
*光学显微镜
*恒温摇床
*小型发酵罐(20L容量)
*低温保藏箱
*恒温培养箱
*无菌瓶
*比色管(25ml容量)
*移液枪(1000微升,10ml,200微升)
*磁力搅拌器
*培养皿(90ml容量)
*载玻片
*试管
*烧杯
*锥形瓶

4.菌种
贝莱斯芽孢杆菌菌株(实验室冷藏保藏)
四、实验方法
第一步:菌种活化
1.取出冷冻斜面培养基。活化的目的和原理
2.用无菌接种环从冷藏箱中取出芽孢杆菌,在斜面表面进行“S”型划线接种。
3.将斜面置于恒温培养箱中培养过夜24h。

如图所示,菌种所需的培养液的配置过程
第二步:液体摇瓶培养
活化与纯化的原理-挑选-变异性
1.观察斜面菌落生长,加入少量无菌水,使用接种环刮取菌体混匀成菌悬液。
2.将菌悬液接种至12瓶液体培养基中(每瓶100ml),放入摇床中进行振荡培养。
3.培养24小时后使用分光光度计检测OD600,每瓶取1mL菌液,经蒸馏水稀释100倍后测定。
4.挑选4瓶生长最好的菌液备用。
如图所示,左图把稀释后的菌液用分光光度计检测后的数值记录,右图是用革兰氏染色法将筛选出来的菌放到光学显微镜下观察生长状态
第三步:分离纯菌株
均匀短杆状,长不长芽孢
1.用涂布棒沾取筛选出的菌液平涂在装有培养基的培养皿中,放入恒温培养箱培养24h
2.用接种环挑选培养皿中生长状态较好的菌取样,采用四区划线法在平板上分离单菌落。
3.平板在恒温箱中培养至单菌落明显形成。

如图所示,左图是平涂培养的培养皿,右图是挑选出的单菌落采用四区划线法后放入恒温培养箱培养24h后
第四步:小罐发酵与结果检测
1.将挑选的纯菌株扩增后,接种至20L发酵罐中。罐内预先加入配好的液体培养基。
2.发酵过程设置合适温度、通气量、搅拌速度等参数。
3.从入罐起(晚上18:00),每隔2小时取样,使用格兰仕染色法并在光学显微镜下观察芽孢形成情况。
4.每隔4小时使用DNS法检测一次发酵液中的还原糖浓度,评估生长状态。
5.到次日10:00,芽孢数量达到80%及以上,作为发酵终点。
6.发酵结束后,80摄氏度水浴加热10分钟发酵后的菌液检测发酵后的芽孢率;用梯度稀释法,稀释到10-8,分别取10-7-8,进行涂布平板法,每个浓度涂布三个平板,检测发酵后的芽孢数量
7.发酵结束后,酸解法分解总糖,DNS检测法
五、实验结果
1.芽孢形成观察结果
在发酵过程中,使用革兰氏染色法每隔2小时进行一次显微镜下的芽孢观察。从第14小时开始,芽孢数量显著增加;至第16小时观察时,芽孢数量达到峰值,占据大多数菌体,表明芽孢形成过程已经基本完成,适宜结束发酵阶段

2.活菌生长情况分析(OD600)
使用分光光度计测定不同时间点菌液的OD600值以判断菌体生长状况。从实验结果可见,发酵2\至2小时内OD值稳定增长,在第12小时达到最大值0.79,之后有所下降。
3.生长状态及pH变化
菌体生长过程中pH呈现出先下降后回升的趋势,说明发酵过程中产生了有机酸等代谢物,后期由于代谢缓解,pH回升。
4.总糖和还原糖含量变化
使用DNS法测定了发酵液中总糖和还原糖的变化情况。实验结果表明,总糖浓度逐渐下降,从初始的46.45g/L下降至第16小时的18.13g/L,说明菌体大量利用糖源进行代谢。还原糖浓度在前期波动增加,后期趋于稳定。
六、结论与讨论
本实验成功完成芽孢杆菌的激活、摇瓶筛选、小罐发酵全过程。过程中掌握了标准微生物操作方法,如斜面培养、四区划线法、OD检测、显微镜观察及发酵取样分析。结果表明:所筛选菌株在小罐中生长稳定,芽孢形成时间集中、效率高,培养基配方适宜。为后续进一步开展高效产芽孢研究提供了实验基础。